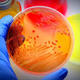
Imagen micro

-
Propone que las enfermedades están causadas por organismos invisibles
-
Zacharias Janssen desarrolla el primer microscopio util compuesto
-
Hace un microscopio compuesto.
Describe a los protozoos.
Describe al los hongos filamentosos -
Publica su trabajo sobre la generación espontánea de gusanos.
Experimentos que descartan la generación espontanea de animales.
"Omne vivo ex ovo" -
Descubre los "animálculos", Hace un microscopio simple y describe a las bacterias.
-
Prepara una vacuna contra la viruela humana a partir del virus de la viruela bovina.
-
La desarrolllan Schwann y Schleiden son los que desarrollan la primera teoria celular.
-
Pasteur demuestra que la fermentación acidoláctica se debe a un microorganismo.
-
Miescher descubre los ácidos nucleicos
-
Koch cultiva bacterias sobre gelatina.
Descubre el bacilo de la tuberculosis Micobacterium tuberculosis.
Se publican por primera vez los postulados de Koch. -
Metchinkoff descrbe la fagocitosis.
Se desarrolla autoclave.
Se desarrolla la tinción de Gram. -
Richard Petri diseña la placa Petri
-
Ivanowsky precenta pruebas de la relación casual entre un virus y la enfermadad del mosaico del tabaco.
-
Buchner prepara un extracto de de levadura que realiza la fermentación Ross demuestra que el parasito del paladismo se transportan por un mosquito.
-
Landsteiner descubre los grupos sanguineos.
-
Wright y otros investigadores descubren anicuerpos en la sangre de animales inmunizados.
-
D'Herelle y Twort descubren virus de bacterias
-
Fleming descubre la penicilina
-
Van Niel demuestra que algunas bacterias fotosintéticas utilizan compuestos reducidos como donantes de electrones sin producción de oxigeno.
-
Ruska desarrolla el primer microscopio electrónico de transmición.
-
Avery demuestra que el DNA transporta información durante la transportación Waksman descubre la estreptomicina.
-
Hershey y Chase muestra que los bacteriografos introducen DNA en las células huésped Zinder y Lederberg descubren la transducción generalizada.
-
Yalow desarrolla la técnica del radioinmunoensayo.
-
Jacob y Monod proponer el modelo operón de regulación de genes.
-
Kohler y Milstein desarrollan una técnica para producir anticuerpos monoclonales.
-
Se desarrollo el microscopio de barrido con efecto túnel.
-
Gallo y Montagnier aislan e identifican el virus de la Inmunodeficiencia humana.
-
Comienzan los primeros análisisen terapia génica humana.
-
Descubrimiento de Thiomargarita namihiensis, la bacteria más grnade conosida.
-
Descubrimiento de que Vibrio cháleme contiene dos cromosomas independientes.
Want to make a timeline like this?
Use Timetoast to turn dates, events, milestones, and phases into a clear visual timeline you can build and share. Timetoast is a timeline maker for work, school, research, and stories.